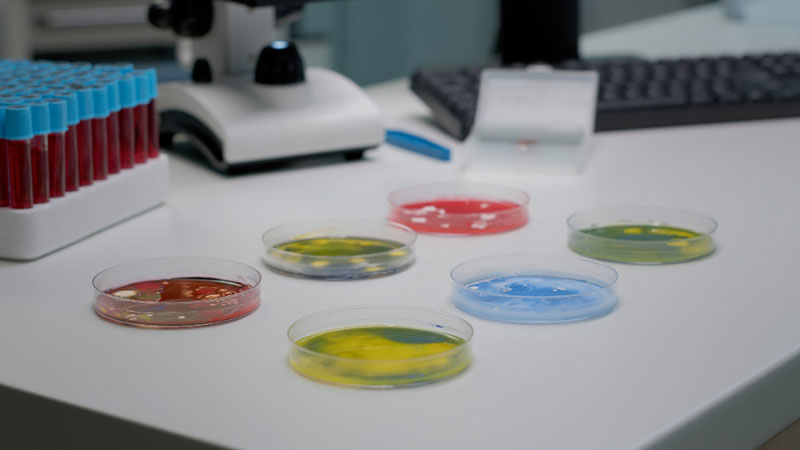
Khi quan sát dưới kính hiển vi, bác sĩ có thể phát hiện các tế bào, vi khuẩn trong nước tiểu

Tin tức
Xét nghiệm nước tiểu bao nhiêu tiền: Thông tin cần biết
- 10/09/2024 | 5 nguyên nhân khiến nước tiểu màu đỏ và cách khắc phục
- 17/09/2024 | Đặc điểm nước tiểu của người bị tiểu đường và cách phòng ngừa biến chứng bệnh
- 21/01/2025 | Giải mã ý nghĩa chỉ số Magie trong các xét nghiệm máu và nước tiểu
- 09/05/2025 | Xét nghiệm nước tiểu khi mang thai: Những vấn đề mẹ bầu nên lưu tâm
- 08/09/2025 | Xét nghiệm nước tiểu bao lâu có kết quả? Nên xét nghiệm ở đâu?
1. Một số thông tin cơ bản về xét nghiệm nước tiểu
Thông qua xét nghiệm nước tiểu, bác sĩ có thể kiểm tra màu sắc, thành phần hóa học cũng như những vi thể trong nước tiểu. Các căn cứ này là thông tin quan trọng hỗ trợ chẩn đoán bệnh lý về gan, thận, nhiễm trùng đường tiết niệu hoặc tiểu đường. Đồng thời, kết quả xét nghiệm nước tiểu còn là căn cứ quan trọng để bác sĩ xác định nguyên nhân gây ra một số bệnh.

Thông qua quá trình phân tích nước tiểu, bác sĩ có thể xác định thành phần hóa học và các vi thể tồn tại trong nước tiểu
Vì chỉ sử dụng nước tiểu nên phương pháp xét nghiệm này không hề gây xâm lấn, an toàn cho người bệnh. Thực tế, xét nghiệm nước tiểu chủ yếu được chỉ định trong những trường hợp dưới đây:
- Khi bệnh nhân kiểm tra sức khỏe định kỳ: Xét nghiệm nước tiểu có thể là một trong những hạng mục cơ bản trong các gói khám sức khỏe hằng năm.
- Trường hợp cần thử thai: Sự tăng lên của nồng độ hormone hCG là một trong những dấu hiệu mang thai. Vì vậy khi đi khám thai, chị em có thể được chỉ định phân tích nước tiểu.
- Kiểm tra tình trạng sử dụng chất gây nghiện: Khi mới sử dụng cần sa, cocaine, heroin, thuốc lắc, các thành phần trong chất gây nghiện thường được đào thải qua nước tiểu.
- Kiểm tra trước khi phẫu thuật: xét nghiệm nước tiểu là bước đánh giá nguy cơ nhiễm trùng hoặc biến chứng có thể xuất hiện trong và sau phẫu thuật.
- Khi cần chẩn đoán tình trạng nhiễm trùng đường tiết niệu: Xét nghiệm nước tiểu cho phép phát hiện dấu hiệu cảnh báo tình trạng đường tiết niệu bị nhiễm trùng, giúp bệnh nhân chủ động điều trị.
Ngoài ra, xét nghiệm nước tiểu còn được chỉ định cho bệnh nhân bị tiểu đường có khả năng mắc bệnh lý liên quan đến thận. Khi biểu hiện các triệu chứng như đau bụng, đau lưng, đau mỗi khi đi tiểu, đi tiểu nhiều hơn bình thường, bệnh nhân cũng có thể được chỉ định phân tích nước tiểu.
2. Các phương pháp xét nghiệm nước tiểu phổ biến
Để đưa ra chẩn đoán thông qua mẫu nước tiểu thu thập từ bệnh nhân, bác sĩ thường tiến hành phân tích dưới kính hiển vi hoặc dùng đến que thử chuyên dụng.
2.1. Phân tích dưới kính hiển vi
Để xác định sự tồn tại của các tế bào, vi khuẩn, chất nhầy,... nước tiểu sẽ được mang đi phân tích dưới kính hiển vi. Thông tin thu thập được từ quá trình quan sát là căn cứ quan trọng hỗ trợ việc chẩn đoán, xác định tình trạng bệnh lý để đưa ra phác đồ điều trị phù hợp.
Khi quan sát dưới kính hiển vi, bác sĩ có thể phát hiện các tế bào, vi khuẩn trong nước tiểu
2.2. Phân tích dưới sự hỗ trợ của que thử
Ngoài quan sát dưới kính hiển vi, nước tiểu còn có thể được phân tích thông qua sự hỗ trợ của que thử chuyên dụng. Phương pháp phân tích này giúp xác định thành phần hóa học chứa trong mẫu bệnh phẩm.
Dựa vào sự thay đổi màu sắc của que thử, bác sĩ sẽ phần nào đánh giá được chất lượng mẫu thử. Ngoài ra, que thử nước tiểu chuyên dụng còn cho phép xác định mức pH, cùng với đó là protein, bilirubin, glucose, leukocyte esterase và tỷ trọng của nước tiểu.

Phương pháp phân tích nước tiểu bằng que thử
Bên cạnh hai phương pháp trên, bác sĩ đôi khi còn quan sát màu sắc nước tiểu để đưa ra nhận định ban đầu. Trong đó, sự thay đổi bất thường của màu sắc nước tiểu thường liên quan đến bệnh lý về đường tiết niệu, bệnh lây qua đường tình dục, tình trạng mất nước, ảnh hưởng của thuốc hoặc thực phẩm tiêu thụ.
3. Phương pháp lấy nước tiểu thường được áp dụng
Để lấy mẫu nước tiểu phục vụ quá trình xét nghiệm, bác sĩ thường chỉ định một trong hai phương pháp sau:
3.1. Lấy nước tiểu giữa dòng
Bệnh nhân cần lấy mẫu nước tiểu trực tiếp tại viện hoặc phòng khám. Dưới đây là quy trình thực hiện:
- Bước 1: Rửa sạch tay.
- Bước 2: Vệ sinh và lau khô quanh niệu đạo.
- Bước 3: Đi tiểu từ từ, bỏ qua phần nước tiểu đầu dòng.
- Bước 4: Bắt đầu ngừng tiểu và lấy khoảng 30 đến 60ml nước tiểu (dồn vào cốc được nhân viên y tế phát cho).
- Bước 5: Tiếp tục tiểu hết phần còn lại vào bồn cầu.

Trong phần lớn trường hợp, bệnh nhân thường được yêu cầu lấy nước tiểu giữa dòng
3.2. Lấy nước tiểu trong 24 giờ
Kỹ thuật lấy nước tiểu trong 24 giờ chủ yếu được chỉ định cho bệnh nhân có dấu hiệu mắc bệnh lý về thận. Thông qua việc xác định lượng creatinin, khoáng chất, protein, hormone đào thải qua thận, bác sĩ sẽ có thêm căn cứ chẩn đoán. Để lấy mẫu nước tiểu trong 24 giờ, bệnh nhân nên thực hiện theo hướng dẫn sau:
- Bước 1: Chuẩn bị một chiếc bình chứa nước tiểu (dụng cụ này được phát tại cơ sở y tế).
- Bước 2: Bỏ đi lượng nước tiểu trong lần đi tiểu đầu tiên trong ngày sau khi ngủ dậy vào buổi sáng.
- Bước 3: Thu lại toàn bộ phần nước tiểu trong những lần đi tiểu sau đó trong ngày.
- Bước 4: Chuyển toàn bộ nước tiểu đã thu thập trong 24 giờ đến cơ sở y tế để xét nghiệm.
4. Giải đáp thắc mắc: Xét nghiệm nước tiểu bao nhiêu tiền?
Xét nghiệm nước tiểu không phải kỹ thuật phân tích quá phức tạp. Vậy nên, chi phí khách hàng cần chi trả thường chỉ từ vài chục đến vài trăm ngàn đồng tùy loại xét nghiệm nước tiểu được chỉ định. Mức chi phí cụ thể phụ thuộc vào những yếu tố như kỹ thuật phân tích, gói dịch vụ khách hàng lựa chọn, đơn vị y tế thực hiện. Để cập nhật bảng giá của dịch vụ này, bạn nên liên hệ trực tiếp với cơ sở y tế.

Nếu muốn biết xét nghiệm nước tiểu bao nhiêu tiền, bạn hãy liên hệ với đơn vị y tế
Nếu bạn đang băn khoăn chưa biết chọn xét nghiệm nước tiểu tại đâu, bạn có thể tham khảo thực hiện tại MEDLATEC. Hệ thống Y tế MEDLATEC tự hào là một trong những đơn vị được các chuyên gia và khách hàng đánh giá cao trong lĩnh vực chăm sóc sức khỏe cộng đồng. Thế mạnh nổi bật của MEDLATEC là dịch vụ xét nghiệm với Trung tâm Xét nghiệm đạt chuẩn quốc tế ISO 15189:2022, được Hội Bệnh học Hoa Kỳ cấp chứng chỉ CAP. Ngoài hỗ trợ lấy mẫu phân tích tại viện, đơn vị hiện triển khai dịch vụ lấy mẫu xét nghiệm tận nơi, trả kết quả nhanh qua email, website hoặc qua app My Medlatec.
Nếu có băn khoăn vấn đề xét nghiệm nước tiểu bao nhiêu tiền hoặc cần đặt lịch khám, xét nghiệm tại MEDLATEC, Quý khách vui lòng liên hệ hotline 1900 56 56 56 để được hỗ trợ.
Bình luận ()
Lựa chọn dịch vụ
Quý khách hàng vui lòng lựa chọn dịch vụ y tế theo nhu cầu!